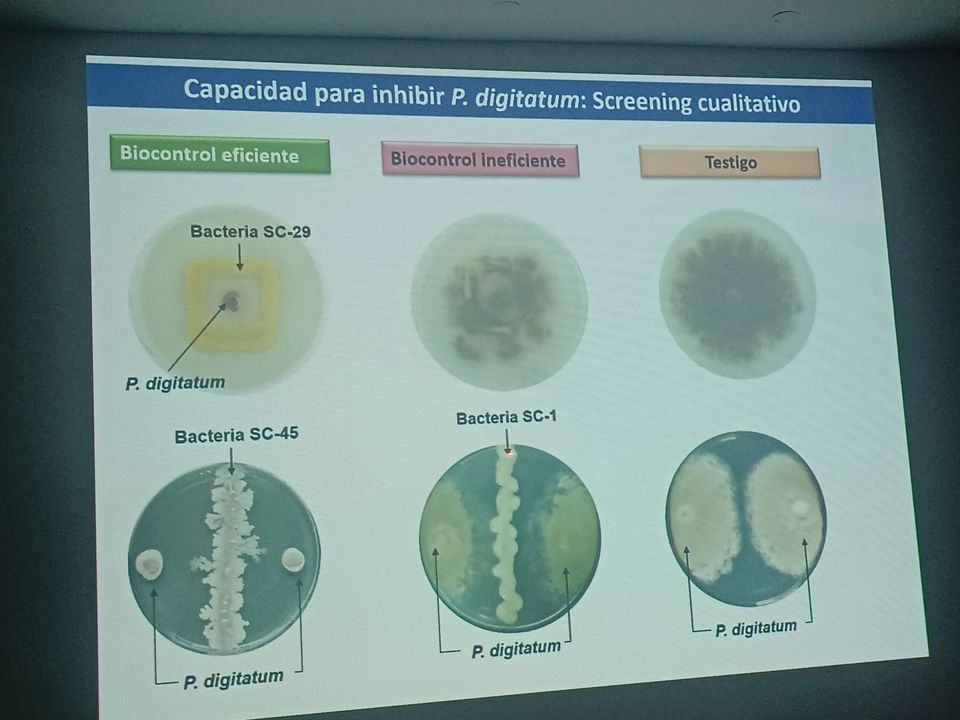
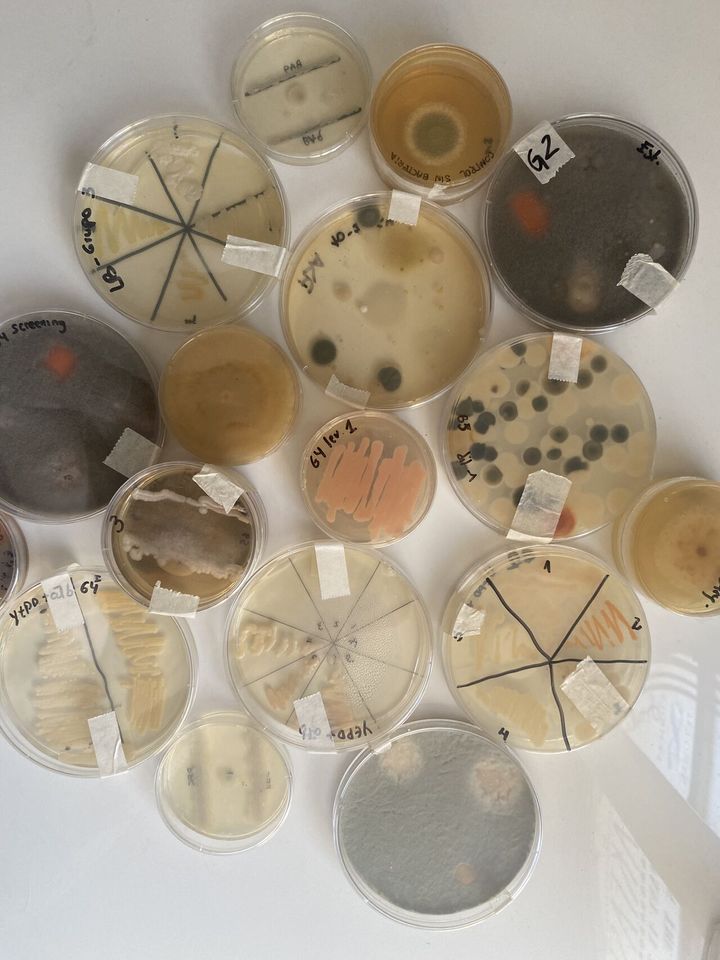

Esse site utiliza cookies
Professores da UFT ministram curso na Argentina
Docentes e acadêmicos da Universidade Federal do Tocantins, com financiamento da universidade da Organização das Nações Unidas (UNU-Biolac), participaram do curso "Postharvest fungal diseases in fruits: the use of sustainable biocontrol strategies" ("Doenças fúngicas em pós-colheita em frutas: o uso de estratégias sustentáveis de biocontrole") no Centro de Pesquisas em Biotecnologia da Argentina (Proimi), nos últimos dias 12 a 16 de agosto. Além da participação nas palestras, foram firmados convênios para realização de pesquisas conjuntas e uma acadêmica fará um doutorado em formato sanduíche.
Segundo o pró-reitor de Pesquisa, Pós-Graduação e Inovação da UFT, professor Raphael Sanzio Pimenta - que foi também um dos palestrantes na Argentina, "foi consolidada uma parceria com a National University of Tucuman (Proimi-Conicet), com o início do período de um doutorado sanduíche da acadêmica Bruna Marcoline, do curso de doutorado em Biodiversidade e Biotecnologia (Bionorte). O estágio sanduíche terá início em março de 2025", disse.
O evento na Argentina teve também palestra da professora Juliana Fonseca, do Programa de Pós-Graduação em Ciências do Ambiente (Ciamb) e do curso de Medicina (Palmas). O evento reuniu os principais pesquisadores da área de microbiologia da América Latina. Os professores Pimenta e Juliana apresentaram os resultados de suas pesquisas, e os estudantes da Rede Bionorte e instituições parceiras receberam informações sobre novas tecnologias na área.
O curso "Postharvest fungal diseases in fruits: the use of sustainable biocontrol strategies" ("Doenças fúngicas em pós-colheita em frutas: o uso de estratégias sustentáveis de biocontrole") foi promovido pela UNU-Biolac e coordenado pelo professor Dr. Julián Dib, do Proimi.
Confira, abaixo. algumas fotos do evento, divulgadas pela UNU-Biolac:

 e Juliana (d) ministraram palestras em curso realizado na Argentina (Foto UNU-Biolac Divulgação).png/thumbnails/imgpreview)